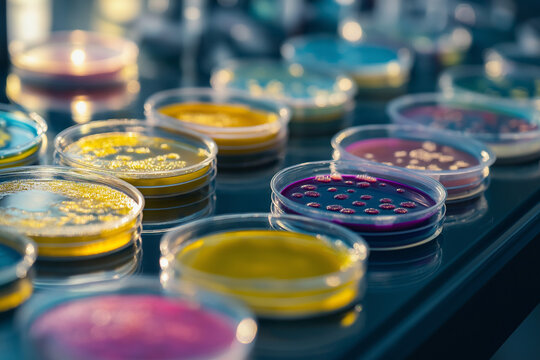
Variety of bacterial colonies and fungal cultures cultivated in multiple petri dishes within a sterile laboratory environment for microbiology research
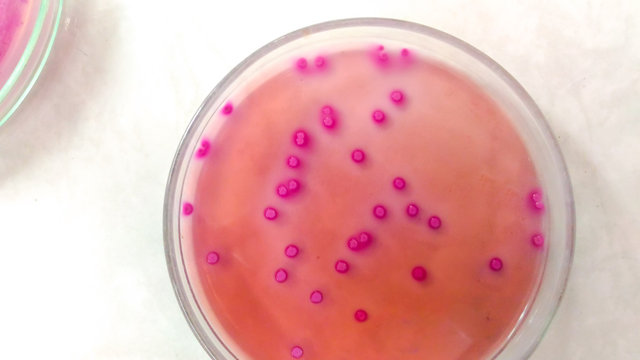
microbiology in laboratory
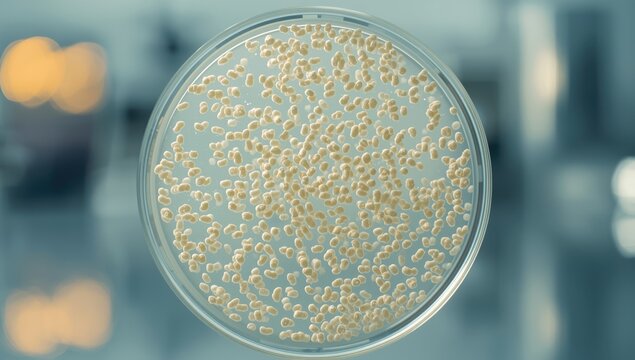
Klebsiella spp. colonies developing on Mac-Conkey agar used in bacterial culture, lab research
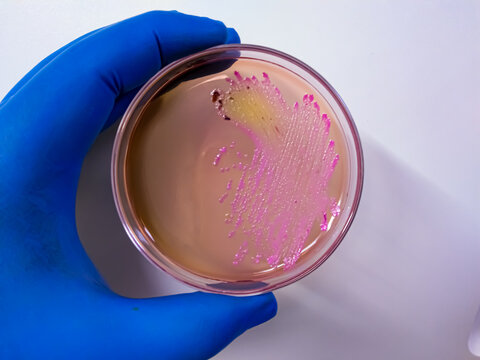
Salmonella Typhi colony on Macconkey agar
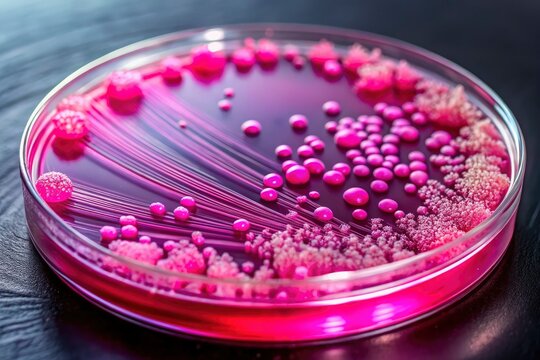
Microscopic pink E. coli colony, meticulously detailed in a high-resolution MacConkey agar subculture image.
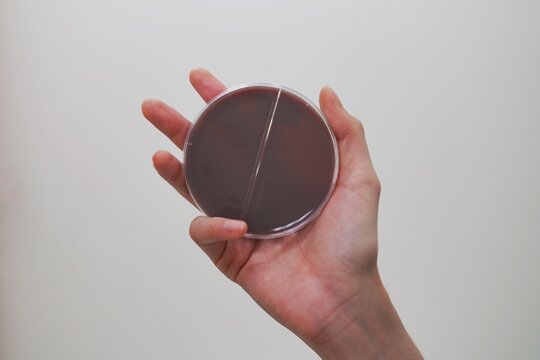
Scientist holding blood agar culture medium plate  for antibiotic resistance test Drug resistant gonorrhea.
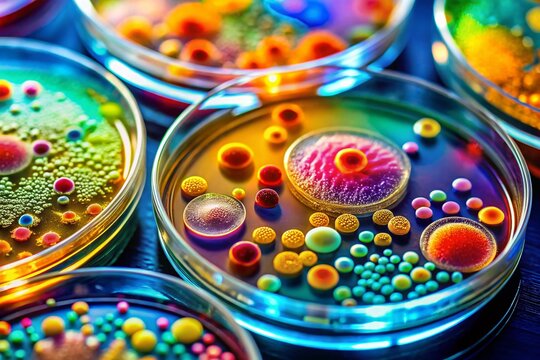
Candid Close-up of Bacterial Colonies Growing on MacConkey Agar Plate in Microbiology Lab
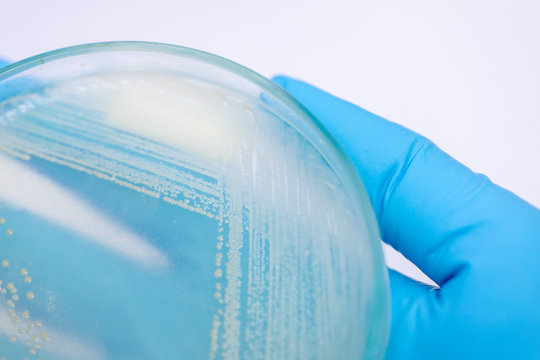
Yeast in petri dish, Microbiology for education in laboratories.
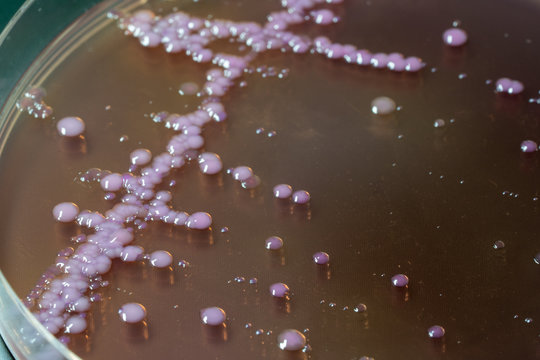
bacterial colonies   on  agar   medium petri dish plate plate on MacConkey agar
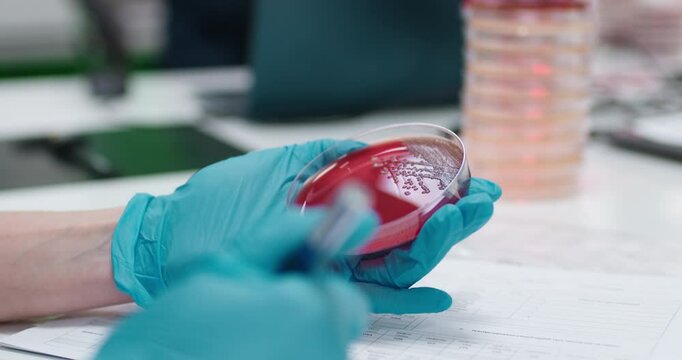
Bacterial colonies ferment lactose on MacConkey agar in the microbiology laboratory.
Concept using Petri dishes to transfer colonies to another plate for further study.
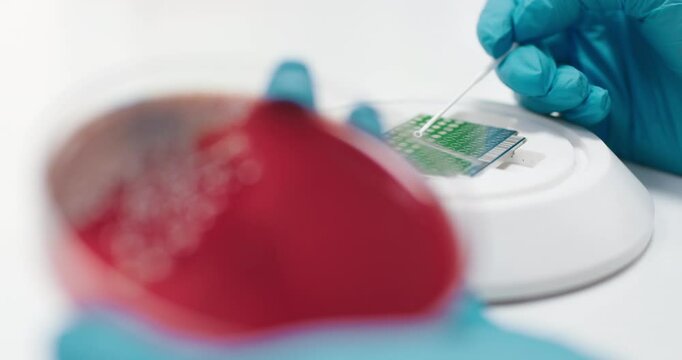
Bacterial colonies ferment lactose on MacConkey agar in the microbiology laboratory during an experiment. Concept studying and diagnosing intestinal infections using specialized culture media.

Free trial: Get 10 stock images, plus AI editing tools
Free trial: Get 10 stock images, plus AI editing tools
New filters added
Sort by
Choose your region
Selecting a region may change the language and promotional content you see on the Adobe Stock web site.
North America
South America
- Venezuela
- Algeria - English
- Armenia - English
- Azerbaijan - English
- Bahrain - English
- Belgium - English
- Belgique - Français
- België - Nederlands
- Česká republika
- Croatia - English
- Cyprus - English
- Danmark
- Georgia - English
- Deutschland
- Eesti
- Egypt - English
- España
- France
- Greece - English
- Iceland - English
- Ireland
Europe, Middle East, and Africa
- Israel - English
- Italia
- Jordan - English
- Казахстан
- Kenya - English
- Kuwait - English
- Киргизия
- Latvija
- Lebanon - English
- Lietuva
- Luxembourg - Deutsch
- Luxembourg - English
- Luxembourg - Français
- Mauritius - English
- Moldova - English
- Hungary - English
- Malta - English
- Morocco - English
- Nederland
- Nigeria
- Norge
- Oman - English